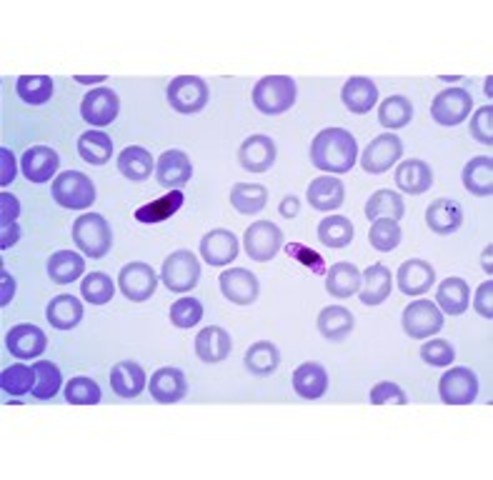
Plasmodium falciparum is described as the causative agent of malaria

-
Plasmodium falciparum is a unicellular protozoan parasite of humans, and the deadliest species of Plasmodium that cause malaria in humans. It is transmitted through the bite of a female Anopheles mosquito. It is responsible for roughly 50% of all malaria cases. It causes the disease's most dangerous form called falciparum malaria.
https://www.cdc.gov/malaria/about/biology/parasites.html -
He performed studies that influenced medicine in the long run. He's known for his discovery of blood in human arteries and for his dissection of the human cranial nerves (nerves that supply key areas of the head, face, and upper chest).
https://www.britannica.com/biography/Galen-of-Pergamum -
Germ theory states that specific microscopic organisms are the cause of specific diseases.These small organisms, too small to see without magnification, invade humans, animals, and other living hosts. Their growth and reproduction within their hosts can cause a disease.The germ theory was proposed by Girolamo Fracastoro
http://ocp.hul.harvard.edu/contagion/germtheory.html -
Lamarck is best known for his Theory of Inheritance of Acquired Characteristics, first presented in 1801. If an organism changes during life in order to adapt to its environment, those changes are passed on to its offspring.
necsi.edu/projects/evolution/lamarck/lamarck/lamarck_lamarck.html -
He worked with two related strands of bacteria which cause pneumonia in mice. He discovered that when harmless live bacteria were mixed with heat-killed disease-causing bacteria and then injected into mice, the mice died. Griffith’s experiment led to the conclusion that genetic material could be transferred between cells.
https://www.brighthub.com/science/genetics/articles/43672.aspx -
e picture. The Beagle, a warship carrying ten cannons, sailed in 1826 to explore the coastline of South America. The ship had an unfortunate episode when its captain sank into a depression, perhaps caused by the isolation of the voyage, and committed suicide.
https://www.thoughtco.com/charles-darwin-and-his-voyage-1773836 -
The theory of spontaneous generation was finally laid to rest in 1859 by the young French chemist, Louis Pasteur. The French Academy of Sciences sponsored a contest for the best experiment either proving or disproving spontaneous generation. Pasteur's winning experiment was a variation of the methods of Needham and Spallanzani.
http://webprojects.oit.ncsu.edu/project/bio183de/Black/cellintro/cellintro_reading/Spontaneous_Generation.html -
Darwin’s theory argued that organisms gradually evolve through a process he called “natural selection.” In natural selection, organisms with genetic variations that suit their environment tend to propagate more descendants than organisms of the same species that lack the variation, thus influencing the overall genetic makeup of the species.
https://www.history.com/this-day-in-history/origin-of-species-is-published-2 -
The genetic experiments Mendel did with pea plants took him eight years (1856-1863) and he published his results in 1865. During this time, Mendel grew over 10,000 pea plants, keeping track of progeny number and type. Mendel's work and his Laws of Inheritance were not appreciated in his time.
https://www.livescience.com/7537-monk-peas-changed-world.html -
The Hardy-Weinberg equilibrium is the fundamental concept in population genetics (the study of genetics in a defined group). It is a mathematical equation describing the distribution and expression of alleles (forms of a gene) in a population, and it expresses the conditions under which allele frequencies are expected to change.
http://www.biologyreference.com/Gr-Hi/Hardy-Weinberg-Equilibrium.html -
A sex linkage is basically when a gene is located on one of the sex chromosomes instead of the other chromosomes (the autosomes). Morgan first person to definitively link the inheritance of a specific trait with a particular chromosome.
http://www.nature.com/scitable/topicpage/thomas-hunt-morgan-and-sex-linkage-Thomas-Hunt-Morgan-and-Sex-Linkage-452 -
The model is just a dense nucleus of protons and neutrons and a large area outside of electrons. Neutrons are located in the nucleus, whereas the electrons are on the outside.
https://www.physicsoftheuniverse.com/scientists_bohr.html -
The Avery–MacLeod–McCarty experiment was an experimental demonstration, reported in 1944 by Oswald Avery, Colin MacLeod, and Maclyn McCarty, that DNA is the substance that causes bacterial transformation, in an era when it had been widely believed that it was proteins that served the function of carrying genetic information
http://www.juliantrubin.com/bigten/dnaexperiments.html -
The Hershey Chase experiments were a series of experiments in 1952 by Alfred Hershey and Martha Chase that helped to confirm that DNA is genetic material. Through their experiments, Hershey and Chase showed that when bacteriophages, which are composed of DNA and protein, infect bacteria, their DNA enters the host bacterial cell, but most of their protein does not.
http://biology-pages.info/H/Hershey_Chase.html -
This photograph was taken in May 1952 by Rosalind Franklin and her PhD student Raymond Gosling at the MRC Biophysics Unit.
Photograph 51 is the nickname given to an X-ray diffraction image of crystallized DNA taken by Raymond Gosling The photograph provided key information that was essential for developing a model of DNA.
https://www.insight.mrc.ac.uk/2013/04/25/behind-the-picture-photo-51/ -
James D. Watson and Francis Crick proposed the double helix structure of DNA in 1953. Watson decide to make new cardboard cutouts of the two bases, to see if perhaps a different atomic configuration would make a difference. It did. Not only did the complementary bases now fit together perfectly, with each pair held together by hydrogen bonds
https://www.nobelprize.org/educational/medicine/dna_double_helix/readmore.html -
The Meselson–Stahl experiment was an experiment by Matthew Meselson and Franklin Stahl with some additional help from a Canadian biologist, Mason MacDonald, and Canadian nuclear physicist, Amandeep Sehmbi, in 1958 which supported the hypothesis that DNA replication was semiconservative.
https://study.com/academy/lesson/what-is-dna-replication-conservative-semi-conservative-dispersive-models.html -
Dr. Margulis was doing reserarch on the origin of eukaryotic cells. She looked at all the data about prokaryotes, eukaryotes, and organelles. She proposed that the similarities between prokaryotes and organelles, together with their appearance in the fossil record, could best be explained by "endo-symbiosis".
https://evolution.berkeley.edu/evolibrary/article/history_24 -
A specific sequence of genes that align up on the different chromosomes in the nucleus of a cell. Genes are composed of DNA molecules which are composed of molecules arranged in a specific order. These DNA molecules split and form patterns and other molecules to attach to and these molecules make different components utilized in the body.
http://www.genomenewsnetwork.org/resources/timeline/1961_Nirenberg.php -
Apollo 11 was the first mission that ever landed on the Moon. The first steps by humans on another planet were by Neil Armstrong and Buzz Aldrin on July 20, 1969. The astronauts came back to Earth the first samples from another planet. This mission was successful, as they were to perform a manned lunar landing and return the mission safely back to Earth.
https://airandspace.si.edu/explore-and-learn/topics/apollo/apollo-program/landing-missions/apollo11.cfm -
In mRNA processing, the spliceosomes binds to the mRNA to cut out introns, which are sections of the mRNA that are not necessary for translation. The spliceosomes is a special complex made up of proteins and small nuclear RNA molecules.
http://cshperspectives.cshlp.org/content/3/7/a003707.full -
In 1977, Frederick Sanger developed the classical “rapid DNA sequencing” technique, now known as the Sanger method, to determine the order of bases in a strand of DNA. Special enzymes are used to synthesize short pieces of DNA, which end when a selected “terminating” base is added to the stretch of DNA being synthesized
http://www.hhmi.org/biointeractive/sanger-method-dna-sequencing -
Scientists exploring the Galápagos Rift along the mid-ocean ridge in the eastern Pacific noticed a series of temperature spikes in their data. They also realized that an entirely unique ecosystem, including hundreds of new species, existed around the vents.
https://www.nationalgeographic.org/media/deep-sea-hydrothermal-vents/ -
The polymerase chain reaction was first developed in 1983 by Kary Mullis. This reaction is commonly used in molecular biology to amplify and generate thousands to millions of copies of specific DNA sequences across several orders of magnitude (4-1). siarchives.si.edu/research/videohistory_catalog9577.html
-
Bacteria in the body are able to defend themselves by cutting up pieces of DNA from invading viruses, storing them in the spaces in the bacteria’s own DNA and recognizing the viruses if they come back. This is known as Clustered Regularly Interspaced Short Palindromic Repeats (CRISPR).
https://www.wolfgreenfield.com/publications/articles/2014/crispr-granahan-loughran-life-sciences-law-and-industry-report -
The Innocence Project is a non-profit legal organization that is committed to exonerating wrongly convicted people through the use of DNA testing and to reforming the criminal justice system to prevent future injustice. The Innocence Project was founded in 1992 by Barry Scheck and Peter Neufeld.
https://www.innocenceproject.org/about/ -
Dolly was a female domestic sheep, and the first mammal cloned from an adult somatic cell, using the process of nuclear transfer. It took scientists 227 tries before producing Dolly.
http://www.animalresearch.info/en/medicaladvances/timeline/cloning-dolly-the-sheep/ -
Sahelanthropus tchadensis is one of the oldest known species in the human family tree. It was discovered by Ahounta Djimdoumalbaye in the southern Sahara desert about 7 and 6 million years ago. This species had a combination of ape-like and human-like features. This skull was evidence that species had a small brain and a sloping face, like a chimpanzee. The size of the skull suggests the individual was a male.
http://www.talkorigins.org/faqs/homs/toumai.html -
The final sequencing mapping of the human genome was brought out on April 14, 2003. In sequencing it is determined the exact order of the base pairs in a segment of DNA. Human chromosomes range in size from about 50,000,000 to 300,000,000 base pairs.
https://www.genome.gov/11006943/human-genome-project-completion-frequently-asked-questions/ -
This man was convicted of molesting and killing a 9-year-old girl in Flagstaff, then executed. http://azdailysun.com/news/local/crime-and-courts/flagstaff-murderer-ricky-bible-executed/article_83b0572d-bc3e-57fc-95c5-a81f7484aecd.html
Plan projects on a visual timeline
Map milestones, phases, deadlines, and key events in one place so the sequence is easier to see and share. Timetoast is a timeline maker for work, school, research, and stories.